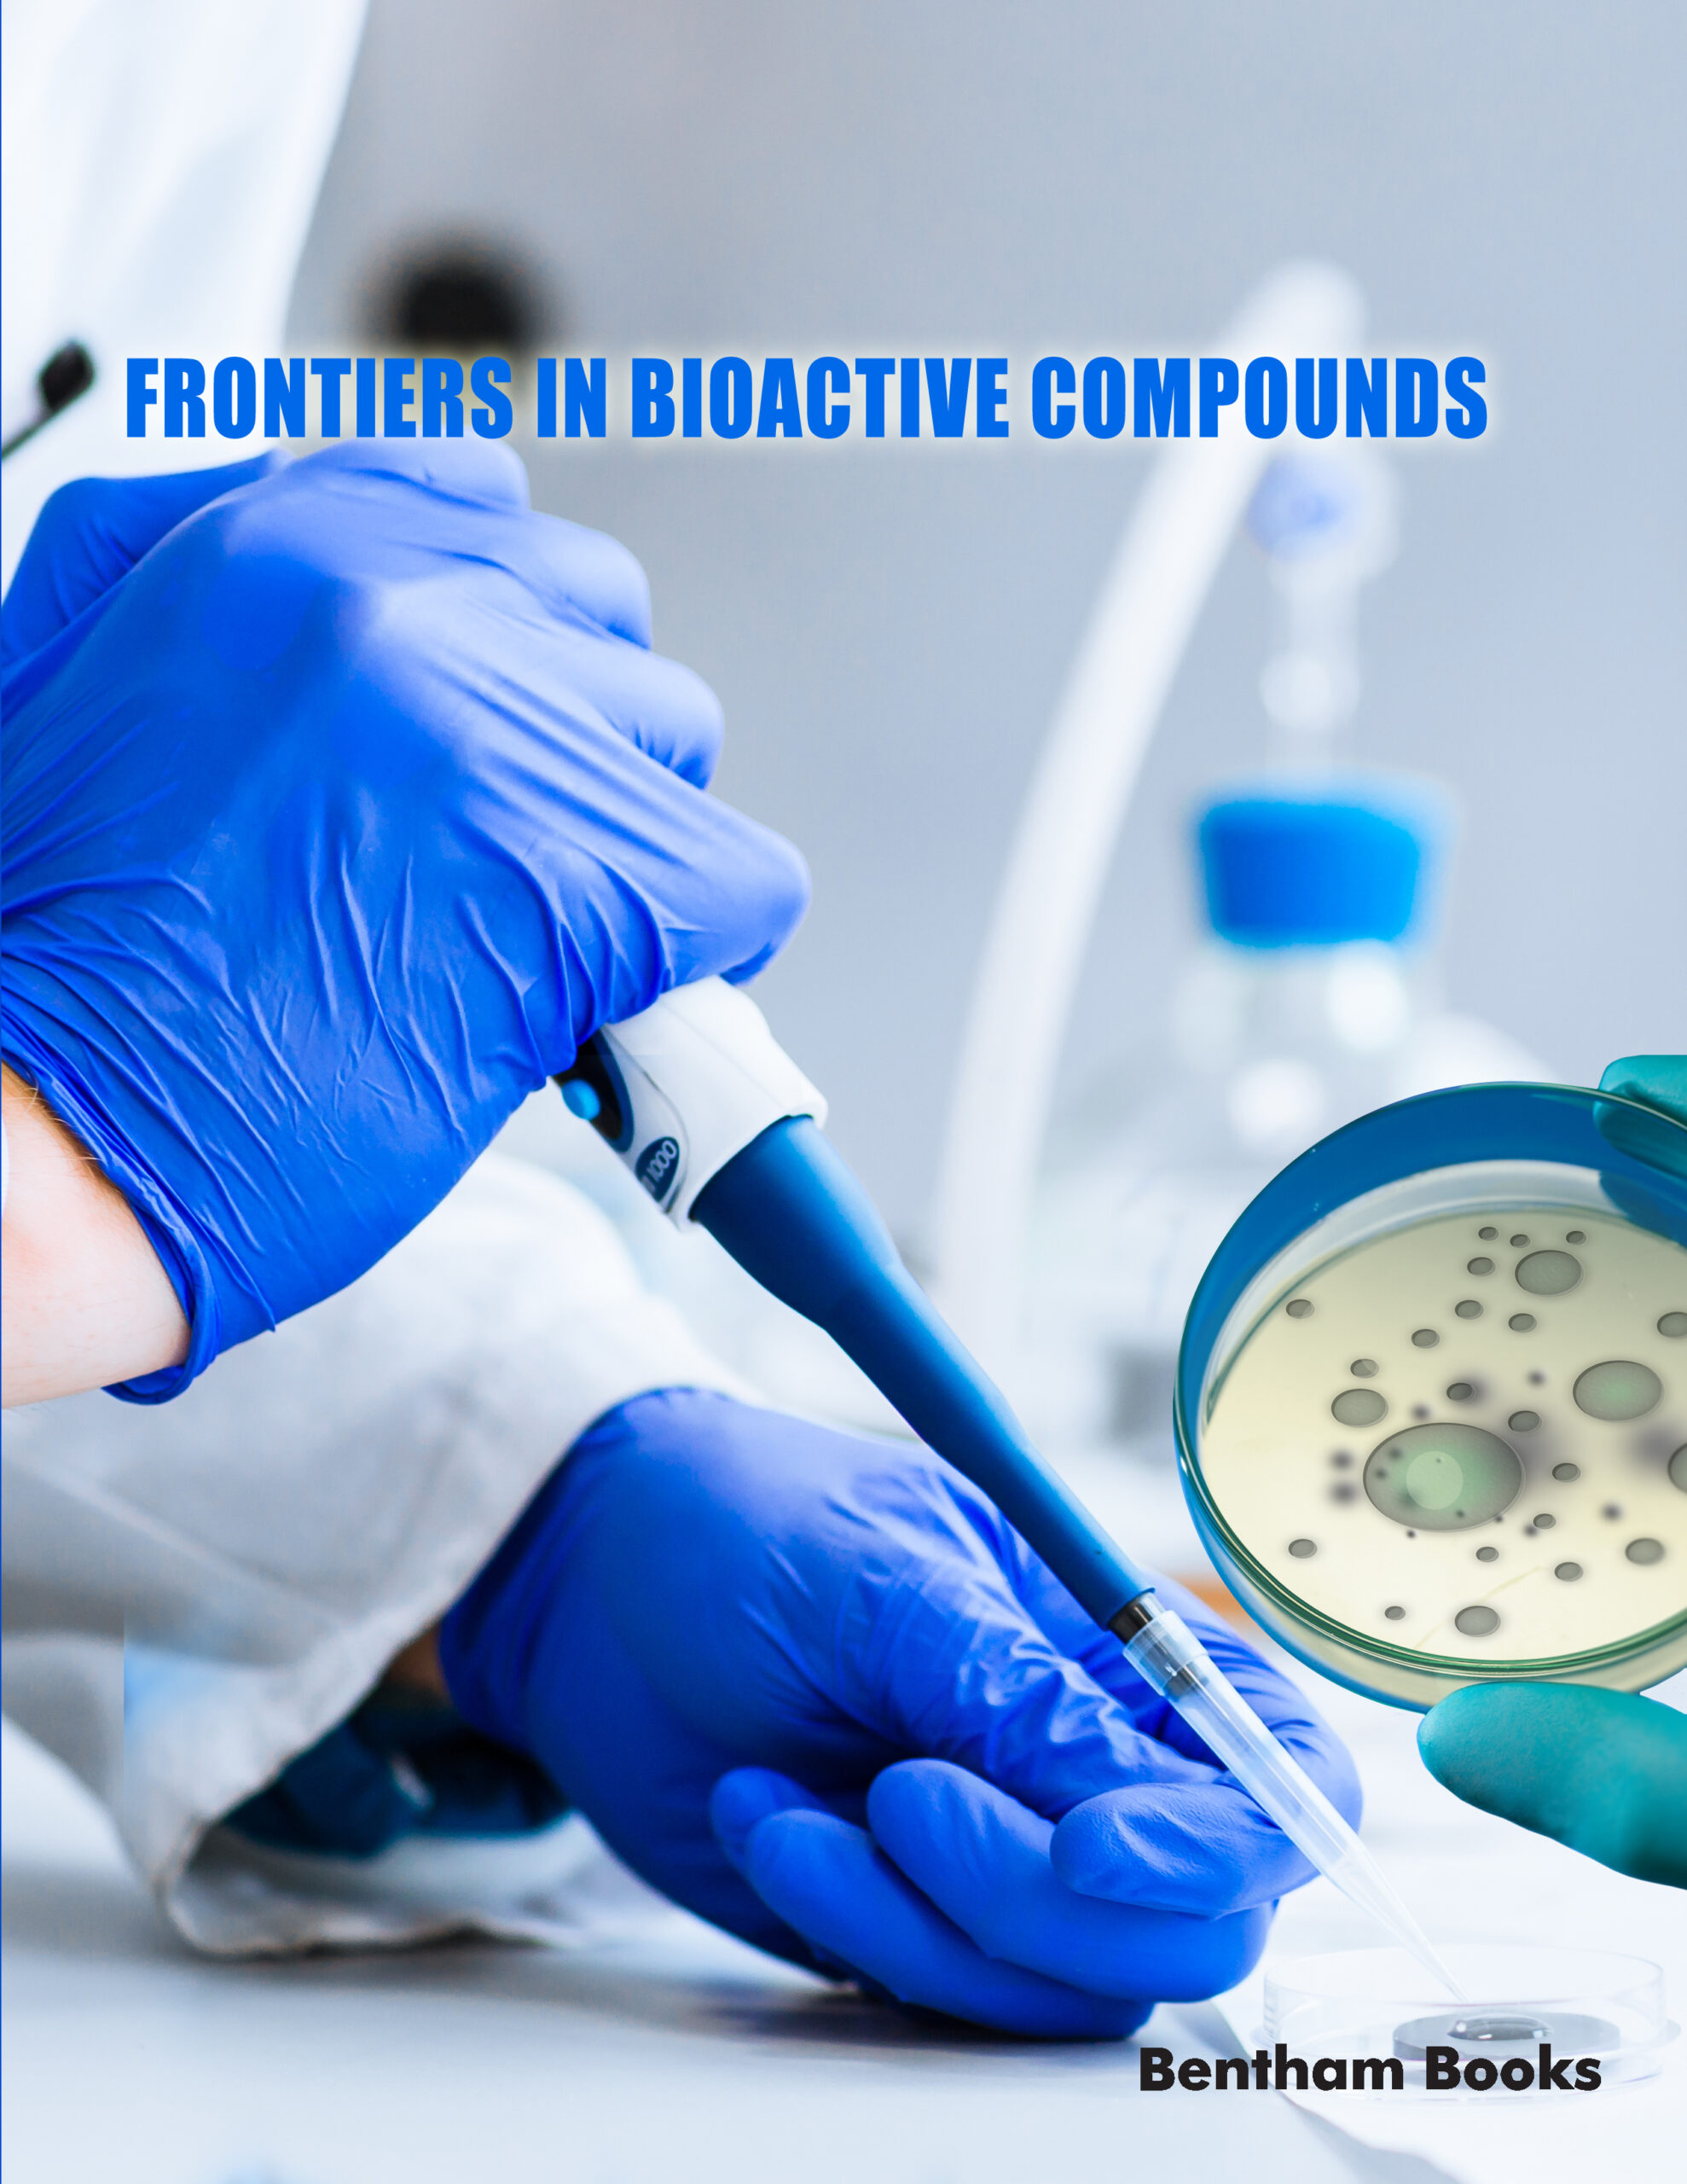

Welcome to your complete guide on betanden. You might have heard this term and wondered what it is, where it comes from, and why it’s gaining attention. This article will break down everything you need to know about betanden in a simple, easy-to-understand way. We’ll explore its origins, its chemical properties, and its various applications across different fields. Our goal is to provide a clear and thorough overview, helping you understand the significance of this fascinating compound. Whether you’re a student, a professional, or just curious, you’ll find valuable information here. We will journey through its scientific background, look at its practical uses, and discuss the ongoing research that continues to uncover its potential.
Key Takeaways
- What is Betanden?: Betanden is a naturally occurring organic compound found in various plants and some microorganisms, known for its unique molecular structure.
- Chemical Properties: It is characterized by its stability, solubility in certain solvents, and its ability to interact with other molecules, making it a subject of scientific interest.
- Sources: The primary natural sources of betanden include specific root vegetables and beets, though it can also be synthesized in a laboratory for commercial use.
- Applications: Betanden has diverse applications, ranging from agricultural uses as a plant growth regulator to industrial uses as a natural colorant.
- Safety: Generally recognized as safe when consumed in amounts found in food, the safety of concentrated betanden supplements and extracts is still under evaluation.
Unpacking the Definition: What Exactly is Betanden?
At its core, betanden is a naturally derived organic compound. To understand what that means, let’s break it down. “Organic compound” simply means it’s a molecule that contains carbon atoms, which are the building blocks of life on Earth. The “naturally derived” part indicates that it is produced by living organisms, primarily plants. It belongs to a class of compounds known for their distinct structures and biological activity. Think of it as one of nature’s many specialized tools, created for a specific purpose within the plant.
Scientists became interested in betanden due to its unique chemical framework. This structure allows it to participate in various chemical reactions and interact with other biological molecules in interesting ways. Its formal chemical name is quite complex, but for our purposes, understanding it as betanden is perfectly fine. The discovery of this compound opened up new avenues for research, particularly in understanding plant biology and biochemistry. Researchers continue to study how plants synthesize betanden and what role it plays in their survival and growth. This fundamental knowledge is crucial for unlocking its full potential in other applications.
The Historical Discovery of Betanden
The journey of betanden from an unknown plant component to a recognized compound is a story of scientific curiosity and technological advancement. Early botanists and chemists, working centuries ago, often observed unusual pigments and substances in plants. They lacked the tools to isolate and identify them precisely. The initial observations that would eventually lead to the identification of betanden were likely related to the unique coloration of certain plants. Scientists noticed that some extracts had properties that couldn’t be explained by the known compounds of the time.
It wasn’t until the 20th century, with the development of more sophisticated analytical techniques like chromatography and spectroscopy, that researchers could finally isolate and characterize betanden. They were able to purify the compound from plant extracts and determine its exact molecular structure. This breakthrough was significant because it allowed for a deeper understanding of its properties and functions. The name “betanden” was coined based on its primary source and chemical classification, following scientific naming conventions. This discovery paved the way for targeted research into its biological roles and potential uses, moving it from a botanical curiosity to a compound of scientific and commercial interest.
Betanden vs. Similar Compounds
It is easy to confuse betanden with other similar-sounding plant compounds, but there are key differences. Compounds like betalains, flavonoids, and carotenoids are also pigments or bioactive molecules found in plants, but their chemical structures and functions are distinct from betanden. For instance, carotenoids are responsible for the orange and yellow colors in fruits and vegetables like carrots and pumpkins, while flavonoids contribute to the colors of many flowers and berries.
The primary distinction lies in their core chemical skeleton. The specific arrangement of atoms in the betanden molecule gives it unique properties that others do not possess. For example, its solubility in water versus oil can differ significantly from a carotenoid. Its stability under heat and light also sets it apart. These differences are critical when considering their applications. A food manufacturer choosing a natural colorant must know if the compound will degrade during cooking. Similarly, a researcher studying its biological effects needs to understand how its structure influences its interaction with cells. Recognizing these distinctions is essential for anyone working with or studying these fascinating natural products.
The Chemical Nature of Betanden
Understanding the chemical properties of betanden is key to appreciating its function and potential. As an organic molecule, its structure is built around a carbon backbone. This structure includes specific functional groups—arrangements of atoms that determine how the molecule behaves and reacts. These groups influence its solubility, melting point, and stability. For example, some parts of the molecule might be hydrophilic (water-loving), while others are hydrophobic (water-fearing), affecting how it dissolves in different liquids.
One of the most studied aspects of betanden is its stability. Like many natural compounds, it can be sensitive to factors such as pH (acidity), temperature, and light. When exposed to harsh conditions, its chemical structure can break down, causing it to lose its properties. This is a critical consideration for any practical application. For instance, if used as a food additive, it must remain stable throughout the product’s shelf life. Scientists have spent considerable time studying the degradation pathways of betanden to find ways to protect it, such as using antioxidants or specific packaging to shield it from light and oxygen. This ongoing research aims to enhance its utility in various industries.
Molecular Structure and Composition
The molecular formula of betanden provides a precise count of the atoms it contains. More importantly, its structural formula shows how these atoms are connected. The betanden molecule is characterized by a complex ring system, which is a hallmark of its chemical family. This intricate arrangement is not accidental; it is precisely assembled by enzymes within the plant’s cells.
Key Structural Features
- Ring System: A central component of the betanden molecule is its multi-ring structure, which provides rigidity and defines its overall shape.
- Functional Groups: Attached to this ring system are various functional groups, such as hydroxyl (-OH) groups, which can influence its solubility and reactivity.
- Stereochemistry: The three-dimensional arrangement of the atoms in betanden is also crucial. Different spatial arrangements, known as isomers, can have vastly different biological effects.
This specific architecture is directly responsible for its unique color, reactivity, and biological activity. Advanced analytical methods, such as Nuclear Magnetic Resonance (NMR) and X-ray crystallography, have been used to map out this 3D structure in great detail. Understanding this blueprint allows chemists to predict how betanden will interact with other molecules and even to design synthetic versions with modified properties.
Natural Sources of Betanden
Betanden is not something you will find everywhere in nature; it is biosynthesized by a select group of plants. The most well-known and commercially significant source of betanden is the common beet root (Beta vulgaris). The deep, vibrant red color of beets is due in large part to a class of pigments to which betanden is related. The concentration of betanden in beets can vary depending on the specific cultivar, growing conditions, and time of harvest. Farmers and food producers often select beet varieties specifically for their high pigment content.
Beyond beets, betanden can also be found in smaller quantities in the leaves and stems of the same plant, as well as in other related species. Some other plants, like certain varieties of amaranth and prickly pear cactus, also produce similar compounds. The presence of betanden in these diverse species suggests it may play a fundamental role in plant physiology, possibly related to stress response or attracting pollinators. Researchers continue to screen different plant species for the presence of betanden, hoping to find new, more potent, or more easily extractable sources. The search for alternative sources is important for ensuring a stable supply chain and potentially discovering new variants of the molecule.
Extraction and Purification Process
Getting pure betanden from its natural source is a multi-step scientific process. The journey begins with harvesting the plant material, such as beetroots. The first step is typically mechanical processing, which involves washing, peeling, and crushing the beets to break down the plant cell walls and release the cellular contents, including the betanden. This creates a raw, colorful juice or pulp.
This raw extract is a complex mixture containing not only betanden but also sugars, proteins, fibers, and other plant compounds. To isolate the betanden, scientists use various purification techniques.
- Filtration: The raw juice is first filtered to remove solid particles like cell debris and fiber.
- Chromatography: This is the most crucial step. The filtered liquid is passed through a column packed with a special material. Different molecules in the mixture travel through the column at different speeds. Because of its unique chemical properties, betanden sticks to the column material differently than sugars or other pigments. By carefully controlling the process, scientists can wash away the unwanted components and then elute (wash out) the pure betanden.
- Concentration and Drying: The purified betanden solution is often too dilute for practical use. It is concentrated, usually under vacuum to avoid heat damage, and then dried into a stable powder form. Techniques like spray drying or freeze-drying are commonly used to create a fine, high-purity betanden powder ready for use in research or commercial products.
Applications and Uses of Betanden
The unique properties of betanden make it a valuable compound in several industries. Its most widespread application is as a natural colorant, particularly in the food and beverage sector. With growing consumer demand for clean labels and natural ingredients, manufacturers are increasingly replacing synthetic dyes with plant-based alternatives like betanden. It can be found in products like yogurt, ice cream, fruit juices, and confectionery to provide appealing red or pink hues. The stability of the color can be a challenge, so food technologists often combine it with other ingredients or use special processing methods to protect it.
In agriculture, research is exploring the use of betanden as a biostimulant or plant growth regulator. Some studies suggest that when applied to crops, it can help plants better withstand environmental stresses such as drought or high salinity. It may work by influencing the plant’s own physiological and biochemical processes, leading to improved growth and yield. This is an exciting area of sustainable agriculture, aiming to enhance crop resilience without relying on synthetic chemicals. The exact mechanisms are still being investigated, but the potential to improve food security through natural means is a powerful motivator for this research.
Industrial and Manufacturing Roles
Beyond food and agriculture, betanden has potential roles in other industrial settings. For instance, in the cosmetics industry, there is an interest in using it as a natural pigment in products like lipsticks and blushes. Similar to the food industry, the “natural” and “plant-derived” marketing angles are very appealing to consumers. However, formulation challenges remain, as the compound must be stable within the cosmetic base and safe for topical application.
Another potential area is in the development of “smart” materials or sensors. Because the color of betanden can change in response to shifts in pH, it could theoretically be incorporated into materials that act as visual indicators. For example, it could be used in packaging to indicate whether a product has spoiled or in scientific test strips to provide a simple color-based reading. While these applications are largely in the experimental stage, they highlight the versatility of the betanden molecule. As our ability to manipulate and stabilize the compound improves, we may see it appear in a wider range of technical and industrial products.
|
Industry Sector |
Primary Use of Betanden |
Key Considerations |
|---|---|---|
|
Food & Beverage |
Natural Red/Pink Colorant |
pH Stability, Heat Sensitivity, Light Degradation |
|
Agriculture |
Biostimulant/Growth Regulator |
Application Method, Concentration, Crop Type |
|
Cosmetics |
Natural Pigment |
Formulation Stability, Skin Safety, Color Consistency |
|
Research & Tech |
pH Indicator, Biological Marker |
Purity, Reactivity, Detection Method |
The Science Behind Betanden’s Effects
The functions of betanden at a biological level are a subject of intensive scientific study. Inside the plant, it is believed to play several roles. One major function is as an antioxidant. Plants, like humans, are susceptible to oxidative stress, which is damage caused by unstable molecules called free radicals. Antioxidants are molecules that can neutralize these free radicals, protecting the cell’s delicate machinery. Betanden appears to be an effective antioxidant, helping to safeguard the plant during periods of stress, such as intense sunlight or attack by pathogens.
Furthermore, scientists are investigating how betanden interacts with animal and human cells in a laboratory setting. In vitro (test tube) studies have explored its potential effects on various cellular pathways. Research in this area is focused on understanding the fundamental mechanisms of action. For example, how does the betanden molecule cross the cell membrane? Which proteins or enzymes inside the cell does it interact with? Answering these questions is the first step toward determining if it has any potential for future therapeutic applications. It is crucial to remember that these are preliminary laboratory findings, and much more research is needed to understand its effects in whole living organisms.
Research and Clinical Studies on Betanden
The body of scientific literature on betanden is growing steadily. Most of the research to date has been preclinical, meaning it has been conducted in laboratories using cell cultures or in animal models. These studies are designed to explore the compound’s basic safety profile and to get a preliminary idea of its biological activities. For example, animal studies might investigate how betanden is absorbed, distributed, metabolized, and excreted by the body. This is known as ADME (Absorption, Distribution, Metabolism, Excretion) profiling and is a standard part of compound development.
As of today, large-scale human clinical trials on pure, isolated betanden are limited. Most human studies have involved the consumption of foods that are rich in betanden-related compounds, such as beet juice. These studies look at overall health outcomes and can provide valuable clues, but they cannot definitively attribute the effects to betanden alone, as these foods contain many other bioactive compounds. Future research will need to include well-designed, placebo-controlled clinical trials using purified betanden to rigorously evaluate its effects on human health. This type of research is expensive and time-consuming but is the gold standard for establishing efficacy and safety.

Safety and Regulation of Betanden
When betanden is consumed as part of whole foods like beets, it is universally considered safe and has been part of the human diet for centuries. Regulatory agencies like the U.S. Food and Drug Administration (FDA) classify beet-derived colorants as exempt from certification, meaning they have a long history of safe use. When used as a food additive, betanden must meet strict purity standards and is used in quantities that are deemed safe for consumption. Food manufacturers are responsible for ensuring that their use of betanden complies with all relevant regulations.
The safety profile becomes more complex when considering highly concentrated betanden extracts or supplements. In these forms, the dose can be significantly higher than what one would get from a normal diet. The regulatory status of such products can vary by country. In the United States, a concentrated betanden supplement would likely be regulated as a dietary supplement. Manufacturers are responsible for ensuring their products are safe and that any claims they make are truthful and not misleading. However, unlike pharmaceutical drugs, supplements do not require FDA approval before they are marketed. As with any supplement, it is wise to consult with a healthcare professional before use.
The Future of Betanden Research
The future for betanden looks bright and full of potential. One of the most exciting frontiers is in the field of synthetic biology. Scientists are exploring ways to engineer microorganisms like yeast or bacteria to produce betanden more efficiently and sustainably than extracting it from plants. This process involves inserting the genetic instructions for making betanden into the microorganism, effectively turning it into a tiny “factory.” This could lead to a purer, more consistent, and potentially cheaper supply of the compound, which would open up new possibilities for its use.
Another key area of future research is to gain a more detailed understanding of its biological mechanisms. Advanced “omics” technologies—like genomics, proteomics, and metabolomics—will allow scientists to see how betanden affects the entire network of genes, proteins, and metabolites within a cell. This systems-biology approach can reveal unexpected interactions and pathways, providing a much richer picture of its effects. This knowledge will be crucial for developing more targeted and effective applications, whether in agriculture, medicine, or industry. The journey of understanding betanden is far from over, and the coming years are likely to yield many more exciting discoveries.
The continuous exploration of natural compounds like betanden highlights our ever-evolving relationship with the natural world. As technology advances, we unlock deeper secrets from plants that have been with us for millennia. For anyone interested in the intersection of chemistry, biology, and industry, this is a field to watch. You can learn more by checking out various scientific resources; for instance, at ReelsAround you can find content that touches upon creative and technical fields. General information about the plant families that produce compounds like this can often be found on platforms like Wikipedia, which offers a broad overview of topics such as the Caryophyllales plant order.
Frequently Asked Questions (FAQ)
Is betanden a vitamin?
No, betanden is not a vitamin. Vitamins are specific organic compounds that an organism needs in small quantities for proper metabolic function but cannot produce on its own. While betanden is a natural organic compound, it is not classified as an essential vitamin for humans.
Can betanden cause any side effects?
When consumed in foods like beets, betanden is safe for the vast majority of people. The most common “side effect” is beeturia, a harmless condition where urine or stool turns reddish. In concentrated supplement form, the potential side effects are not well-studied, and it is always best to consult a healthcare provider.
What is the difference between betanden and betaine?
While both are found in beets and their names sound similar, betanden and betaine are different chemical compounds. Betaine (trimethylglycine) is an amino acid derivative involved in metabolic processes, particularly in liver function. Betanden is a more complex pigment molecule.
How is betanden different from synthetic food dyes?
Betanden is a natural colorant derived from plants. Synthetic food dyes, such as Red 40 or Blue 1, are created artificially in a lab. Consumers are increasingly seeking natural alternatives due to concerns about the potential health effects of some synthetic dyes, leading to the growing popularity of compounds like betanden.
Is betanden stable when heated?
The stability of betanden is sensitive to heat. High temperatures, especially for prolonged periods, can cause it to degrade and lose its color. Food manufacturers who use betanden as a colorant must carefully control their processing temperatures to maintain the final product’s appearance.

